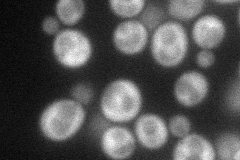
YGL229C
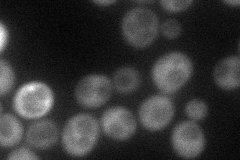
YGL229C
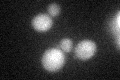
YGL229C

View description
Protein required for function of the Sit4p protein phosphatase, member of a family of similar proteins that form complexes with Sit4p, including Sap155p, Sap185p, and Sap190p
Localization:
Intensity:
Fold change:
Significance:
-
C’ GFP library in SD

below threshold18.96 -
N' NOP1pr-GFP in SD
cytosol61.3303 -
N' TEF2pr-mCherry in SD
cytosol34.534 -
N' NATIVEpr-GFP in SD

ambiguous17.8498 -
N' TEF2pr-VC and Cyto-VN in SD

#N/A0 -
C’ GFP library in SD+DTT
cytosol17.230.9No -
C’ GFP library in SD+H2O2

cytosol18.790.99No -
C’ GFP library in Starvation Media

cytosol15.320.8No -
C’ GFP library on the background of Pup2-DaMP

below threshold -
C’ GFP library on the background of CCT mutant

below threshold18.31360.96538No
